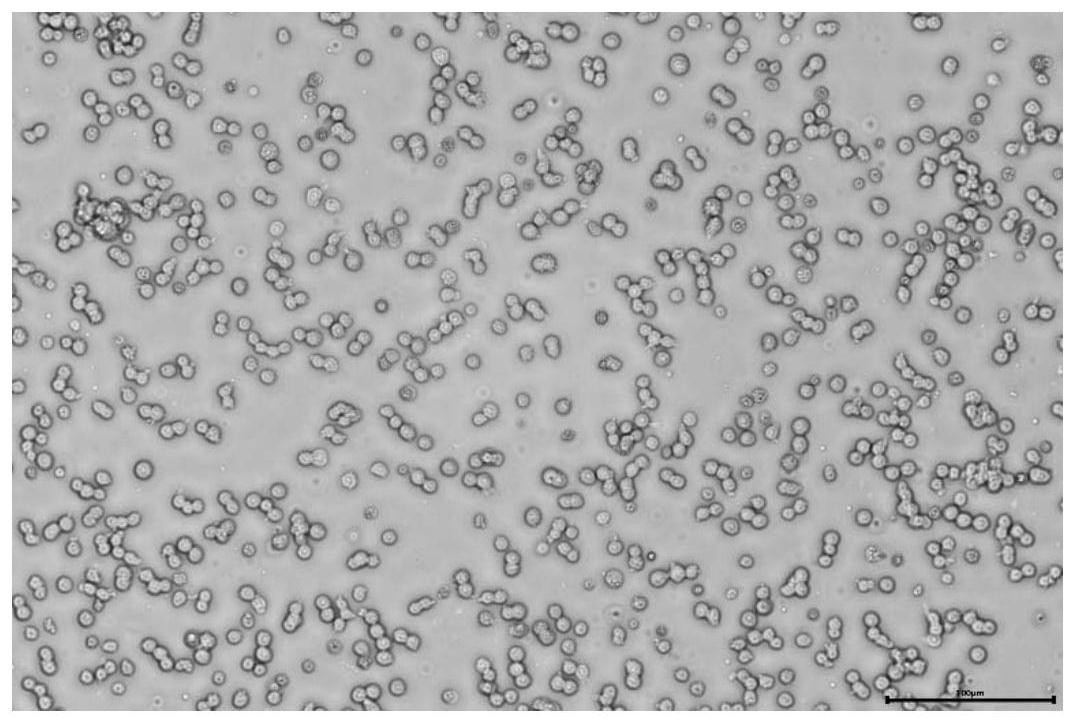
一种使用全悬浮细胞测定鸡新城疫病毒含量的方法

悬浮细胞

【转帖】【分享帖】常见悬浮细胞
图片尺寸1024x768
悬浮细胞怎么培养看这里
图片尺寸1242x875
【转帖】【分享帖】常见悬浮细胞
图片尺寸2048x1536
悬浮细胞,请问图片中是什么,是污染吗
图片尺寸3264x2448
【转帖】【分享帖】常见悬浮细胞
图片尺寸1024x768
昆虫细胞悬浮培养形态
图片尺寸583x444
无血清悬浮型lmh细胞系及其制备方法和应用
图片尺寸1410x2385
【求助】悬浮细胞培养状态很差,细胞成团,细胞上有很多毛毛点点的东西
图片尺寸5184x3456
2%鸭红细胞悬浮液100ml鸿泉生物新鲜无菌细胞观察科研实验用试剂
图片尺寸533x512
一种使用全悬浮细胞测定鸡新城疫病毒含量的方法
图片尺寸1075x723
【求助】悬浮细胞培养状态很差,细胞成团,细胞上有很多毛毛点点的东西
图片尺寸5184x3456
培养的悬浮细胞死亡
图片尺寸780x1052
【转帖】【分享帖】常见悬浮细胞
图片尺寸1024x768
293f悬浮细胞生长是否正常-1
图片尺寸675x900
【转帖】【分享帖】常见悬浮细胞
图片尺寸1024x768
【求助】悬浮细胞培养
图片尺寸1280x1280
手机照的,比较模糊,悬浮细胞,很多细胞不能同时对焦.
图片尺寸2368x4208
16hbe细胞突然多了很多悬浮黑点!求小伙伴救救孩子!
图片尺寸4908x3264
这个细胞是悬浮 贴壁的,图片看应该是没有吹打均匀,细胞本身是不大的.
图片尺寸1252x915
贴壁悬浮混合型细胞--培养方法及注意事项_cm_部分_离心管
图片尺寸720x478